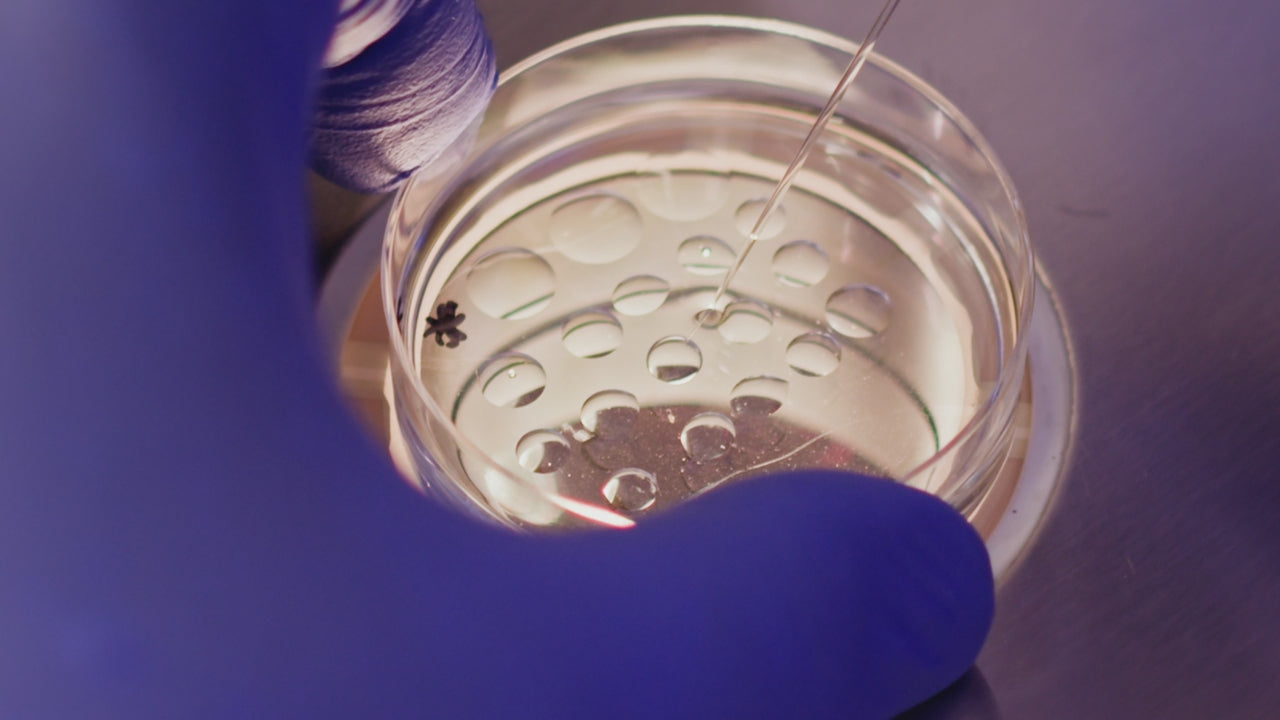

Everything in One Place
IVF Store is your one-stop shop for everything IVF — offering trusted products, responsive support, and simple, single billing. From dishes and media to cryo tools and pipettes, we’ve gathered everything you need to keep your lab running smoothly. IVF Store is your gateway to better selection, better service, and a better way to order.
Dishes for IVF
Set up for success with MEA-tested dishes for oocyte retrieval, insemination, embryo culture, and transfer.

Small Culture Dishes

Large Culture Dishes

Extra Large Dishes

Center Well Dishes

ICSI Dishes

4 & 5 Well Dishes

Multi-Well Dishes

Cryopreservation Dishes
Tubes for IVF
Sterile, embryo-safe tubes for sperm prep, oocyte collection, and aliquoting.
Great Selection
Our tubes are available from multiple brands, ready for use with MEA testing and certification

Sample Tubes

Collection Tubes

Centrifuge Tubes
IVF Pipettes
Handle gametes and embryos with precision — from dish prep to denuding.

Glass Pipettes

Serological Pipettes

Pipette Tips

DeNoody Tips

IVF Store is your one-stop shop for everything IVF, with trusted products, great service, and simple, single billing. Complete your lab with confidence and make ordering easier than ever.
Sperm Preparation
Prepare samples with care using IVF Store’s trusted range of sperm preparation media, density gradients, and devices designed for optimal recovery and motility.

Semen Collection

Sperm Counting

Sperm Preparation Media

Harvester
Oocyte Retrieval
From aspiration needles to collection tubes, IVF Store offers everything you need for safe, effective oocyte retrieval with products trusted by IVF professionals nationwide.

Needles

Pumps

Probe Covers

Needle Guides

Glass incubators

Ultrasound Gel

Dry Heater Blocks

Denuding/Stripping

Biohazard

Gloves
Embryo Culture
Support healthy development with high-performance embryo culture media and incubators to enhance embryo viability from fertilization to blastocyst.

Culture Media

Culture Oil
We provide everything needed for optimal embryo growth

Incubators

QC
Cryopreservation
Protect your most precious samples with cryopreservation tools and media for vitrification and slow-freezing, including embryo, oocyte, and sperm storage solutions.

Vitrification Devices

Vitrification/Warming Media

Vitrification Boxes

Cryo Tags

Canes

Goblets

Sleeves

Dishes

CryoStorage

Monitoring


Selection Is Everything!
What you’re seeing here is just the beginning. With over 1,000 IVF-certified products and new items added weekly, IVF Store is here to make sure you never have to compromise. Whether you’re standardizing your workflow or trying something new, our team is ready to help you find the right fit — and deliver with speed, service, and simplicity.
Micromanipulation Pipettes
Explore our complete selection of micromanipulation pipettes for ICSI, biopsy, hatching, and transfer, handcrafted for consistency and precision under the microscope.

ICSI Pipettes

Biopsy Pipettes

Holding Micropipettes

Specialty Biopsy Pipettes
Embryo Transfer
Ensure smooth and successful embryo transfers with our carefully selected range of ET catheters, trial catheters, and support tools trusted by leading IVF labs.

Syringes

ET Catheters

Specula